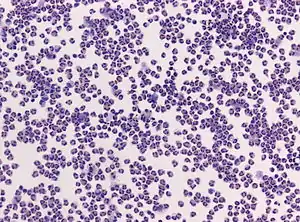

Менінгококова інфекція
Менінгоко́кова інфе́кція (синонім Менінгококова хвороба, англ. meningococcal infection or meningococcal disease) — гостре антропонозне інфекційне захворювання з повітряно-крапельним механізмом передавання, яке спричинює Neisseria meningitidis. Хвороба може перебігати у вигляді субклінічного ураження носоглотки, або її явного запалення (назофарингіт), або менінгококцемії чи гнійного менінгіту, рідше — з ураженням інших органів і систем.
| Менінгококова інфекція | |
|---|---|
![]() Дитина з Нової Зеландії на ім'я Шарлотта Кліверлі, що захворіла на тяжку форму менінгококової інфекції — менінгококцемію (уражені гангреною руки і ноги довелося ампутувати). Дитина з Нової Зеландії на ім'я Шарлотта Кліверлі, що захворіла на тяжку форму менінгококової інфекції — менінгококцемію (уражені гангреною руки і ноги довелося ампутувати). | |
| Спеціальність | інфекційні хвороби |
| Симптоми | гарячка, біль у горлі, головний біль, висип, септичний шок, менінгіт і менінгеальні симптоми |
| Причини | менінгокок |
| Метод діагностики | фізикальне обстеження, мікробіологічна культура і ПЛР |
| Препарати | ампіцилін, цефотаксим, цефтріаксон і кортикостероїди |
| Класифікація та зовнішні ресурси | |
| МКХ-11 | 1C1C |
| МКХ-10 | A39 |
| DiseasesDB | 8847 |
| MedlinePlus | 000608 |
| MeSH | D008589 |
| SNOMED CT | 23511006 |
| | |
Історичні відомості
З давніх часів відомі епідемії, які за клінічним описом могли бути менінгококовою інфекцією та відомі під назвами «френіт», «петехіальна гарячка», «епідемічна цефальгія». Перші достовірні клінічні описи, скоріше за все, однієї з форм менінгококової інфекції — менінгококового менінгіту, зробили у XVII столітті видатні англійські лікарі Томас Вілліс й Томас Сиденгам. У самостійну нозологічну форму так званий тоді «епідемічний цереброспінальний менінгіт» виділили у 1805 році, коли швейцарський лікар Гаспар Вієссю задокументував першу його епідемію на околицях Женеви тривалістю 3 місяці з 33 смертями. Хоча в 1884 році італійські науковці Етторе Маркіафава та Анджело Челлі знайшли диплокок у спинномозковій рідині при розтині померлого, але пов'язав збудника із виникненням менінгіту австрійський бактеріолог Антон Вексельбаум, який у 1887 році в шести випадках менінгіту виявив та описав менінгокок під назвою «внутрішньоклітинний менінгітний диплокок». У 1898 році американський дослідник Н. Гвін виявив цього диплокока в крові. У 1901 році австрійські вчені Г. Альбрехт та А. Гон отримали збудника у чистій культурі, докладно вивчили його властивості, патологічні зміни в організмі людини, виявили субклінічну форму менінгококової інфекції, вперше знайшли аглютиніни у коней у відповідь на введення менінгокока. У 1902 році німецький дослідник Г. Саломон виявив хронічну менінгококцемію. У 1918—1920 роках американський лікар В. В. Геррік сформулював кардинальні засади патогенезу менінгококової інфекції, виділивши 3 стадії процесу:
- на слизових дихальних шляхів;
- у крові;
- на мозкових оболонах.
У 1929 році англійський мікробіолог Д. Мюррей відніс збудника до на той момент вже відомого роду Neisseria та дав йому сучасну назву. У 1911 році англійський лікар Р. Вотергауз та у 1918 році данський педіатр К. Фредеріксен незалежно один від одного описали своєрідний характерний синдром (який отримав відповідну назву за їхніми прізвищами) при менінгококцемії, як її ускладнення, що обумовлений крововиливом у кору надниркових залоз із формуванням гострої надниркової недостатності.
Актуальність
Захворюваність на менінгококову інфекцію протягом останніх років становить від 1 до 5 на 100 тис. осіб у економічно розвинених країнах, й від 10 до 25 на 100 тис. людей в країнах, що розвиваються. Під час епідемій захворюваність на менінгококову інфекцією доходить до 1 000 на 100 тис. населення. Якщо летальність в доантибіотичну еру досягала 70 %, то нині коливається в межах від 10 до 20 %, сягаючи аж до 40 % при менінгокоцемії. І нині до 20 % осіб, що перенесли тяжкі форми менінгококової інфекції, мають резидуальні наслідки, половина з них отримують інвалідність.

Менінгококова інфекція належить до тих хвороб, «які становлять особливу національну та регіональну проблему»[1] і які регулюють Міжнародними медико-санітарними правилами 2005 року. У країнах Центральної Африки на південь від Сахари від Сенегалу на заході до Ефіопії на сході менінгококова інфекція спричиняє найвищу в світі захворюваність і дуже часті епідемії через кожні 7-14 років із серйозними наслідками. На мапі Африки така регіональна захворюваність виглядає образно як «менінгітний пояс». За епідемічний сезон 2009 р. у 14 африканських країнах, які проводять посилений епіднагляд, було зареєстровано, загалом, 88 199 випадків захворювання, 5 352 з яких закінчились смертю. Це найбільші показники з часу епідемії 1996 р[2]. Найчастіше епідемії там спричинюють серогрупи А, але Міністерство охорони здоров'я Нігеру сповістило ВООЗ про те, що в країні з 1 січня по 27 червня 2015 року відбулась найбільша в «менінгітному поясі» епідемія менігококової інфекції, яку зумовила Neisseria meningitidis серогрупи С. Захворіло 8 500 осіб, зокрема померло 573[3]. Менінгококова інфекція створює серйозні проблеми у Саудівській Аравії під час хаджу. Спостерігають значні спалахи цієї хвороби, через що країна вимагає від паломників наявність сертифікату про щеплення проти менінгококової інфекції.
Щороку на планеті фіксують 300—500 тисяч випадків менінгококової інфекції, з яких 30-50 тисяч стають летальними, що наводить у Фейсбуці український Центр громадського здоров'я[4]. Але згідно із зарубіжними джерелами тільки менінгококовий менінгіт, який є однією з клінічних форм менінгококової інфекції, в усьому світі дає щонайменше 1,2 мільйона випадків на рік, від нього гине близько 135 000 хворих[5].
Етіологія
Збудником захворювання є менінгокок або Neisseria meningitidis, представник роду Neisseria, родини Neisseriaceae. Це грамнегативний диплокок, що має характерну бобоподібну або у вигляді кавових зерен форму, аероб і факультативний анаероб. У мазках з патологічного матеріалу розташовується переважно внутрішньоклітинно.
Детальніші відомості з цієї теми ви можете знайти в статті Менінгокок.
Епідеміологічні особливості
Джерело та резервуар інфекції
Хвороба належить до антропонозів, зустрічається повсюдно. Джерелом та резервуаром інфекції є людина, що має субклінічну форму (носійство) хвороби, а також хворі на назофарингіт, генералізовану форму. Носійство менінгококів серед людей розповсюджено достатньо широко і підлягає коливанням. Вважають, що 10-20 % людей в світі є носіями N. meningitidis у будь-який момент часу[2]. Співвідношення між хворими та носіями непостійне (за різними даними, від 1:2 000 до 1:50 000). У періоди спорадичної захворюваності 1-3 % населення можуть бути носіями менінгокока, в епідемічних осередках — до 20-30 %. Тривалість носійства становить 2-3 тижні. Більш тривале носійство пов'язане, як правило, з хронічними запальними ураженнями носоглотки.
Механізм і шляхи передачі
Механізм передачі інфекції — повітряно-крапельний. Збудник передається з крапельками слизу при кашлі, чханні, розмові. Внаслідок нестійкості менінгокока у зовнішньому середовищі і його локалізації на слизовій оболонці задньої стінки носоглотки, він передається при досить тісному і тривалому спілкуванні, у закритих та напівзакритих, новостворених відкритих колективах. У сім'ях, де стався випадок менінгококової інфекції, ризик зараження інших членів зростає у 400—800 разів.
Сприйнятливий контингент та імунітет
Природна сприйнятливість людей висока, але результат зараження визначається як властивостями збудника (вірулентність), так і резистентністю макроорганізму. Менінгококову інфекцію реєструють в усіх вікових групах: від перших днів життя до похилого віку. Тим не менш, це типова «дитяча» інфекція, діти до 5 років складають понад 70 % всіх хворих. Після перенесеної хвороби зберігається тривалий імунітет. Повторні захворювання відмічають у людей з вродженим дефіцитом компонентів комплементу С7-С9.
Найтяжчий тягар менінгококової інфекції лежить на районах африканського «менінгітного поясу». Під час сухого сезону між груднем і червнем вітри, що несуть пил, холодні ночі та інфекції верхніх дихальних шляхів завдають шкоди слизовій оболонці носоглотки, підвищуючи ризик менінгококової інфекції. В той же час передачі N. meningitidis можуть сприяти обмежені житлові умови і переміщення населення у великих масштабах на регіональному рівні у зв'язку з паломництвом і традиційними ринковими відносинами. Саме поєднанням усіх чинників пояснюється те, що в сухий сезон у «менінгітному поясі» відбуваються великі епідемії.
Патогенез
Розвиток субклінічного ураження
Вхідними воротами інфекції служать слизові оболонки носоглотки, де формується субклінічна форма (носійство), тому що в більшості людей на момент зараження гуморальний імунітет в змозі не дати менінгококу проникнути в кровоток, а на поверхні слизової достатньо захисних секреторних антитіл, що утворюються, як вважають, через високий рівень колонізації слизової непатогенною Neisseria lactamica. Наявність у неї спільних групових антигенів з іншими нейссеріями призводить до того, що коли на слизову потрапляють безкапсульні форми менінгококів, вони досить ефективно знешкоджуються наявними антитілами до Neisseria lactamica, хоча вони й не здатні їх повністю елімінувати. Захисну дію мають й антитіла, що індукуються через колонізацію слизових й окремими бактеріями, наприклад, непатогенними ешеріхіями, Bacillus pumilus. Менінгококи чіпляються до клітин слизової за допомогою наявних у них відростків-пілей, а рецептором клітин слизової є поверхневий протеїн CD46[6].
Розвиток назофарингіту
Лише в 10-15 % випадків через слабкість місцевого захисту потрапляння менінгокока на слизову оболонку носа і глотки призводить до розвитку запалення (назофарингіт). Це відбувається у людей із зниженням рівня пропердину, з дефектами у системі комплементу (С3, С5-9) при аспленії. Сприяють виникненню назофарингіту наявність хронічних уражень (синусіти, отит, вазомоторний риніт), куріння, попереднє ураження носоглотки збудниками ГРВІ, мікоплазмами.
Генералізація із спричиненням менінгококцемії
Ще рідше менінгокок здатний подолати місцеві носоглоткові захисні бар'єри. Це можуть тільки такі збудники, що захищені капсулою. Основний шлях поширення збудника в організмі людини — гематогенний. Ті ж самі фактори сприяють цьому, як і у випадку виникнення місцевих продуктивних уражень. Бактеріємія може бути транзиторною або тривалою (менінгококцемія). У патогенезі менінгококцемії провідним є інфекційно-токсичний шок (ІТШ), обумовлений масивною бактеріємією з інтенсивним розпадом менінгококів і токсинемією. Ендотоксиновий удар призводить до цитокінового викиду, розладів гемодинаміки, перш за все — мікроциркуляції, синдрому диссемінованого внутрішньосудинного згортання (ДВЗ-синдрому), глибоких метаболічних розладів (гіпоксія, ацидоз, гіпокаліємія тощо). Розвиваються порушення згортання і протизгортання крові: спочатку переважає процес гіперкоагуляції (збільшення вмісту фібриногену та інших факторів згортання), потім відбувається випадання фібрину в дрібних судинах з утворенням тромбів. Патоморфологічно шкірні висипання є бактеріальними тромбами з перифокальним ураженням судин і екстравазатами. У результаті тромбозу судин більшого калібру може розвинутися гангрена кінцівок. Подальше зниження вмісту фібриногену в крові (коагулопатія споживання) нерідко стає причиною масивних кровотеч і крововиливів у різні тканини і органи.
Розвиток менінгіту, менінгоенцефаліту
При проникненні менінгококу до мозкових оболон (гематогенно, периневрально, контактно) розвивається клінічна і патоморфологічна картина менінгіту. Менінгококи проникають через гематоенцефалічний бар'єр (ГЕБ) всередині фагоцитів. Іноді менінгіт відбувається на тлі менінгококцемії, але частіше виникає як самостійна форма. Запальний процес розвивається спочатку у м'якій і павутинної оболонах (обумовлюючи синдром менінгіту), а потім може периваскулярно поширюватися на речовину мозку, частіше обмежуючись зовнішнім шаром кори, досягаючи білої речовини (синдром енцефаліту). Характер запалення у перші години серозний, потім — гнійний. Перетворення гною на щільні фібринозні маси відбувається до 5-8-го дня. При ураженні епендими шлуночків виникає епендиматит. При порушеннях циркуляції ліквору ексудат може накопичуватися в шлуночках, що призводить (у маленьких дітей) до гідроцефалії, численних лікворологічних розладів у дорослих. Підвищення внутрішньочерепного тиску може призводити до зміщення мозку вздовж церебральної осі й вклинення мигдаликів мозочка у великий потиличний отвір з вдавленням довгастого мозку і смертю від паралічу дихання.
Рідкі ураження
Проникнення менінгококів у кров не завжди веде до менінгококцемії, можливі й окремі органні ураження. Потрапляння збудника до серцевих структур призводить до: ендокардиту, перикардиту, міокардиту, панкардиту. Іноді можливі артрити, ураження очей у вигляді кон'юнктивіту, невриту очного нерва. В дуже рідких ситуаціях системні й органні ураження можуть перебігати тривало, навіть хронічно.
Клінічні прояви
Класифікація
Згідно МКХ-10 вирізняють в класі «Деякі інфекційні та паразитарні хвороби», блоці «Інші бактеріальні хвороби» під кодом А39 «Менінгококову інфекцію». Всередині цього коду виділяють:
- «Менінгококовий менінгіт» (А39.0);
- «Синдром Вотергауза — Фредеріксена» (А39.1);
- «Гостру менінгококцемію» (А39.2);
- «Хронічну менінгококцемію» (А39.3);
- «Неуточнену менінгококцемію» (А39.4);
- «Менінгококову хворобу серця» (А39.5), яка в свою чергу включає:
- «кардит» (I52.0);
- «ендокардит» (I39.8);
- «міокардит» (I41.0);
- «перикардит» (I32.0);
- «Інші менінгококові інфекції» (А.39.8), які в свою чергу включають:
- «артрит» (M01.0);
- «кон'юнктивіт» (H13.1);
- «енцефаліт» (G05.0);
- «ретробульбарний неврит» (H48.1);
- «постменінгококовий артрит» (M03.0);
- «Менінгококову інфекцію неуточнену» (А39.9);
Носійство менінгокока
Включають в код «Менінгококова інфекція неуточнена» (так само, як і ринофарінгит або назофарингіт) виявляють тільки при масовому обстеженні в осередку менінгококової інфекції, а також випадково при взятті мазків зі слизової оболонки носоглотки. Клінічно виявити носіїв неможливо через відсутність будь-яких симптомів.
Назофарингіт
Може бути самостійною клінічною формою менінгококової інфекції або продромальною стадією генералізованої форми. Інкубаційний період при цій формі варіює в межах 1-10 днів, але частіше становить 3-5 діб. Захворювання починається гостро, хворі скаржаться на кашель, першіння, біль у горлі, закладення носа, нежить із слизисто-гнійним виділеннями. Провідною скаргою у більшості хворих є тупий головний біль, який найчастіше локалізується в лобно-тім'яної області. Є певна млявість, адинамія, блідість обличчя. При фарингоскопії можна виявити гіперемію піднебінних мигдаликів, м'якого піднебіння і дужок, гіперемію і зернистість задньої стінки глотки, покритої слизисто-гнійним нашаруванням. Дуже часто на задній поверхні глотки ці виділення утворюють дві характерні смужки по ходу стікання їх з хоан. У деяких випадках пальпують збільшені і болісні підщелепні лімфатичні вузли. Ця форма нагадує звичайні ГРВІ, перебігає у більшості випадків легко, і нерідко хворі виявляються лише при активному обстеженні осередка інфекції. При середньо-тяжкому перебігу спостерігаються явища загальної інтоксикації, виражена температурна реакція, артеріальна гіпотензія, тахікардія, приглушеність тонів серця, запаморочення. Захворювання закінчується повним одужанням хворих. Однак, іноді може відбуватися достатньо тяжкий перебіг із розвитком вираженого синдрому інтоксикації: різкий головний біль, гарячка, короткочасна менінгеальна симптоматика і геморагічний висип на шкірі, що створює певні проблеми в трактовці діагнозу: чи це тяжкий перебіг ринофарингіту, чи початок генералізації. Більшість клініцистів схиляються до думки, що в подібній ситуації слід визначити це саме як начальні прояви генералізації інфекції з відповідними тактичними змінами в веденні хворого.
Менінгококова пневмонія
Зустрічається рідко, спричинюється переважно серогрупою W135 менігокока, може бути осередковою або частковою, зазвичай характеризується тяжким перебігом. Етіологічна діагностика можлива тільки при виявленні збудника в мокроті. Її класифікаційно також відносять до коду «Менінгококова інфекція неуточнена».

Менінгококцемія (менінгококовий сепсис)
У більшості випадків розвивається після попереднього назофарингіту, іноді — на тлі повного здоров'я. Ця форма менінгококової інфекції зустрічається в усіх вікових групах і характеризується гострим початком, підвищенням температури тіла, що досягає за кілька годин 40-41°С. При огляді хворого відзначають блідість обличчя з ціанотичним відтінком, задишку, тахікардію. Виражена схильність до значного зниження артеріального тиску (АТ), може розвинутися колапс. Основна клінічна ознака, що дозволяє розпізнати менінгококцемію — характерний геморагічний висип, що зазвичай з'являється на 1-у добу захворювання, рідше висипання утворюються трохи пізніше. Патогномонічні для менінгококцемії геморагічні елементи різної величини, від яскраво-червоного до темно-червоного або фіолетового відтінку, мають неправильні обриси зірчастого характеру, щільні на дотик і злегка виступають над шкірою. Висипання відбуваються неодночасно, тому різні елементи висипу у одного й того ж хворого мають різну кольорово-формову характеристику. Жоден з елементів не нагадує інші ані за формою, ані за відтінком забарвлення, ані за розміром. У середньому, елементи розміром 3-7 мм у діаметрі. При тяжких формах захворювання розміри геморагічних елементів можуть досягати 5-15 см і більше, з некрозом шкіри у центрі. Висип частіше розташовується на сідницях, нижніх кінцівках, у пахвових западинах, на тулубі, верхніх повіках і має тенденцію до зливання. У дорослих зазвичай на обличчі висипань немає (окрім повік). Поява висипу на обличчі є ознакою тяжкого перебігу. Екзантема у дуже тяжких випадках може набувати генералізованого характеру, розташовуючись на будь-якій ділянці тіла, великі елементи висипу в центрі часто піддаються некрозу. Нерідко геморагічний висип виникає разом з розеольозним чи розеольозно-папульозним. Зворотний розвиток висипу залежить від його характеру і розповсюдженості ураження. Розеоли і розеольозно-папульозні елементи зникають швидко і не залишають слідів. На місці значних за площею крововиливів нерідко утворюються некрози з наступним відторгненням некротичних ділянок і утворенням дефектів. Можливий також некроз дистальних фаланг пальців, стоп, вушних раковин, у дітей — навіть гангрена кінцівок. Геморагічний синдром при менінгококцемії проявляється також крововиливами у кон'юнктиви, склери, слизову оболонку ротоглотки. Можливі носові, шлункові, маткові кровотечі, мікро- і макрогематурія, субарахноїдальні крововиливи.
На ранніх термінах хвороби можуть з'явитися ознаки ураження суглобів; при цьому в перші дні захворювання зазвичай виникають ураження дрібних суглобів кисті, а на 2-му тижні хвороби — великих суглобів (колінний, тазостегновий, плечовий). Хворі відзначають виражену болісність в ураженому суглобі при рухах. При об'єктивному огляді звертає на себе увагу гіперемія і набряклість шкіри. Суглобова рідина може бути серозно-гнійного характеру, проте виділити з неї збудник, як правило, не вдається. У більш тяжких і запущених випадках ексудат носить гнійний характер, в ньому виявляють менінгококи. Прогноз, як правило, сприятливий: набряклість і гіперемія шкіри зникають протягом 2-4 днів лікування. Хоча можуть бути випадки розвитку постменінгококового артриту (скоріше, артрозу-артриту).
Тяжким проявом менінгококцемії, нерідко з летальним результатом, є синдром Вотергауза-Фредеріксена, що характеризується розвитком тяжкого шоку вже у перші години захворювання. Цей шок має змішаний характер — він обумовлений поєднанням ІТШ, який відбувається через масивну бактеріємією з інтенсивним розпадом менінгококів і токсинемією, та гострою недостатністю надниркових залоз через крововиливи в них. Ці фактори призводять до дуже тяжкої депресії системної гемодинаміки. Захворювання починається з різкого підвищення температури, ознобу. Вже у перші години хвороби з'являється геморагічний висип на тлі виразного ціанозу, через що шкіра має нерідко фіолетове забарвлення, на тлі якого помітні геморагічні елементи. Хвороба швидко прогресує. Висип швидко стає рясним, поряд з численними петехіями і великими геморагіями з'являються великі синці. Хворі бліді, непокоїть невпинне блювання, нерідко блювотиння є кривавим. Можливі носові і маткові кровотечі. АТ прогресивно знижується, пульс частий, ниткоподібний. Наростає ціаноз, деякі ділянки шкіри набувають забарвлення, що нагадує трупні плями. Наростає задишка, з'являється рухове збудження, судоми. Менінгеальний синдром, як правило, різко виражений, хоча іноді може не розвиватися. Температура тіла, спочатку підвищена, знижується до субфебрильної, а нерідко до субнормальної. Розвивається типова картина шоку. Без адекватного лікування смерть може настати через 6-48 годин від початку хвороби.
Хронічний перебіг менінгококцемії спостерігають рідко. Характерними є тривала інтермітуюча гарячка, поліморфний висип на шкірі, артрити та поліартрити, гепатолієнальний синдром.
Менінгококовий менінгіт
Починається, як правило, гостро, з різкого ознобу і підвищення температури тіла до 38-40°С. Лише у частини хворих за 1-5 днів з'являються продромальні явища у вигляді назофарингіту. Захворювання характеризується вираженою загальною слабкістю, болем в очних яблуках, особливо при русі, потім з'являється головний біль в лобово-скроневих, рідше — потиличних областях. Головний біль швидко наростає, стає розлитим, виснажливим, стискаючого або розпираючого характеру. Виникає блювання, що не приносить хворому полегшення. Спостерігається підвищена чутливість до всіх видів зовнішніх подразників (світлобоязнь, гіперакузія), млявість, загальмованість, порушення сну. При тяжких формах характерні порушення свідомості (сомноленція, сопор, кома). Швидко з'являються та наростають об'єктивні симптоми подразнення мозкових оболон (найчастіше ригідність потиличних м'язів, симптом Керніга, нижній симптом Брудзинського). У більшості хворих відзначаються зниження черевних, періостальних і сухожильних рефлексів, а також їх нерівномірність (анізорефлексія). Ураження черепних нервів виявляються в перші дні хвороби і відрізняються зворотністю. Найчастіше уражаються лицьовий нерв, а також окорухові нерви (III, IV і VI пари), рідше — під'язиковий і трійчастий нерви.
Менінгококовий менінгоенцефаліт

Характеризується тяжким перебігом, вираженими енцефалітичними проявами у поєднанні з різким менінгеальним і загальноінтоксикаційним синдромами. Загальномозкова симптоматика наростає швидко. До кінця першої — початку другої доби хвороби розвиваються порушення свідомості у вигляді глибокого сопору, що супроводжується психомоторним збудженням, судомами, нерідко зоровими або слуховими галюцинаціями. Паралельно наростають менінгеальні симптоми. Через добу від початку хвороби у більшості хворих спостерігається характерна менінгеальна поза (хворий лежить на боці з зігнутими ногами і закинутою головою — поза лягавого собаки або зведеного курка). Ознаки енцефаліту виступають на перший план у міру зменшення інтоксикації і набряку мозку. Визначається вогнищева церебральна симптоматика, частіше у вигляді пірамідної недостатності: парез мімічної мускулатури за центральним типом, виражена анізорефлексія сухожильних і періостальних рефлексів, різкі патологічні симптоми, спастичні геми-і парапарези, рідше — паралічі з гіпер- або гіпостезією, координаторні порушення. Вогнищеві ураження речовини головного мозку проявляються також у вигляді ураження черепних нервів. Можуть з'являтися коркові розлади — порушення психіки, часткова або повна амнезія, зорові і слухові галюцинації, ейфорія або депресивний синдром. По цих ознаках клінічно неможливо відрізнити явища енцефаліту від проявів тяжкого набряку-набухання головного мозку (ННГМ), однак більшість клініцистів вважає необхідним трактувати вищеназваний стан саме як менінгоенцефаліт.
Ускладнення
Найбільш грізними ускладненнями і такими, що зустрічаються часто у молодих людей є ННГМ, ІТШ, гостра ниркова недостатність, анкілози суглобів, міокардіосклероз. Також можуть спостерігатися такі ускладнення як тромбози великих судин з наступними некрозами шкіри, гангрени пальців. При тяжкому менінгоенцефаліті можливі пролежні, судомний синдром, синус-тромбоз, сліпота, крововиливи у субдуральний простір або в речовину мозку. У дітей можлива втрата слуху, гідроцефалія, зниження інтелекту.
При можливому зсуві мозку вздовж церебральної осі розвивається вклинення мигдаликів мозочка у великий потиличний отвір зі здавлюванням довгастого мозку. Стан проявляється наростанням ціанозу, м'язовими судомами, згасанням корнеальних рефлексів, розвитком геміпарезу, брадикардією або тахікардією, лабільністю АТ зі схильністю його до зниження. Виникають порушення ритму дихання, а потім його зупинка. Через кілька хвилин спиняється робота серця.
Прогноз на даний момент є більш сприятливим при менінгококовому менінгіті (смертність до 8 %), тоді як при менінгкокоцемії досягає 40 %, при синдромі Вотергауза-Фредеріксена доходить до 80 %.
Діагностика
Клінічна діагностика
Ґрунтується на клінічних та епідеміологічних даних. До числа найбільш важливих клінічних ознак менінгококового менінгіту відносяться: молодий вік, груповий характер захворювань, гострий початок хвороби, виражені симптоми загальної інтоксикації, висока температура тіла, озноб, порушення сну, біль в очних яблуках, м'язах, оглушення або збудження, наростаючий менінгеальний синдром. Враховуючи швидкий перебіг менінгококової інфекції, оптимальними термінами діагностики слід вважати перші 12 годин від початку хвороби. Раціональне лікування, розпочате в ці терміни, призводить до одужання хворих. Клінічна діагностика менігококцемії ґрунтується на появі патогномонічного висипу, яка з'являється на тлі виразної гарячки та інтоксикації із явищами шоку в 1-у добу хвороби у вигляді геморагічних елементів різної форми, відтінку, розмірів з улюбленою локалізацією на сідницях, нижніх кінцівках, у пахвових западинах, тулубі та верхніх повіках і має тенденцію до зливання.

Лабораторна діагностика
У периферичній крові — високий лейкоцитоз із зсувом нейтрофілів вліво, з 2-ї доби — різке підвищення ШОЕ. Рівень змін у крові корелює з тяжкістю перебігу.
У стаціонарі для діагностики менінгококового менінгіту особливе діагностичне значення має люмбальна пункція (пункція спиномозкового каналу, яка виконується, як правило, на рівні поперекового відділу хребта, між IV і V, або III і IV поперековими хребцями) з дослідженням спинномозкового ліквору. Тиск ліквору підвищений. Наприкінці 1-ї доби хвороби він, як правило, вже мутний, за забарвленістю нагадує молоко, яке додано у воду. Є виразний нейтрофільний плеоцитоз, що свідчить про гнійний характер ураження, спостерігається певна клітинно-білкова дисоціація, глобулінові реакції позитивні. Зменшується вміст у лікворі глюкози й хлоридів.
Специфічна діагностика
Основним є бактеріологічний метод. Якщо при типовій менігококцемії клінічна діагностика є головною й вирішальною, то при всіх інших формах необхідне бактеріологічне підтвердження. Піддають дослідженню найчастіше змиви з носоглотки, мокротиння, кров, ліквор. Висів проводять на кров'яний агар. Часто можна підтвердити діагноз й бактеріоскопічно, ґрунтуючись на виявленні в лікворі й крові характерних внутрішньоклітинно розташованих грамнегативних бобоподібних диплококів з спільною капсулою. Взагалі вважають необхідним посів крові на менінгокок у всіх хворих з поєднанням гарячки та петехіального висипу. При епідемічних спалахах в деяких країнах проводять ПЛР. Методи серологічної діагностики, засновані на виявленні антитіл до менінгококу (РНГА) мають допоміжне значення, їх використовують для визначення серотипу збудника.
Лікування
Рано розпочата й адекватна терапія, особливо на початку генералізації інфекції, дає змогу врятувати життя хворого та визначає сприятливий прогноз. Ведучою в лікуванні менінгококової інфекції є етіотропна терапія.
Менінгококовий назофарингіт
Проводять лікування перорально ампіциліном 0,5 4 рази на добу, або доксицикліном 0,1 на добу 5-7 днів, або ципрофлоксацином 0,5 2 рази на добу протягом 5 днів, або азитроміцином 0,5г в 1-й день, по 0,25г 2-5-й день. Також призначають засоби, що зменшують запалення в носоглотці.
Генералізовані форми
Найефективнішим антибактеріальним засобом залишається бензилпеніцилін, який призначають в дозі 2-4 млн. ОД. кожні 4 години чергуючи в/в та в/м введення. Таке дозування і такий режим введення забезпечують подолання ГЕБ і створення достатньої концентрації антибіотика у спинномозковій рідині. Також можна використовувати ампіцилін у дозі 1,0-1,5 г 4-6 разів на день чергуючи в/м та в/в введення, або цефотаксим 2,0 г 4 рази на день чергуючи в/м та в/в, або цефтріаксон 2,0 г 2 рази на добу в/в. Антибіотиком резерву в цій ситуації є левоміцетину сукцинат по 1,0 г 4 рази на день в/м. Навіть при дуже тяжкому перебігу менінгококового менінгоенцефаліту не слід вводити антибіотик в спинномозковій канал, так як це може спричинити небажані наслідки (епендиматіт, спайковий процес, судомний синдром).
Показниками ефективності лікування менінгококового менінгіту є нормалізація температури тіла і покращення стану хворого. На 5-6 добу лікування необхідний контроль спинномозкової рідини. Основний критерій, який надає підставу для припинення антибіотикотерапії — зниження плеоцитозу до 33 клітин в 1 мкл ліквору із переважанням лімфоцитів (75 % і більше). Вміст білка в лікворі може залишатися ще збільшеним.
Лікування менігококцемії сильними бактерицидними антибіотиками може призводити до виникнення ІТШ або поглиблювати вже існуючий. Через це у більшості країн, де відсутні можливості швидкої реанімаційної допомоги, бензилпеніцилін в цьому випадку не рекомендують. Враховуючи переважно бактеріостатичну дію левоміцетину сукцинат є препаратом вибору при менінгококцемії у епізодах, коли ІТШ вже розвинувся. Його призначають по 1,0 г 4 рази на день в/м. При лікуванні хворих у умовах сучасного реанімаційного відділення при відсутності виразного ІТШ на момент початку лікування можливе застосування пеніциліну по 1 млн ОД. 6 разів на добу в/м або ампіциліну по 1,0 г 4 рази на день в/м під прикриттям глюкокортикостероїдів (ГКС).
Поряд з етіотропною терапією в лікуванні менінгіту призначають засоби патогенетичного лікування, для чого використовують розчин глюкози, кристалоїдні полійонні розчини. Детоксикацію та регідратацію слід супроводжувати форсованим діурезом, для чого використовують салуретики разом з осмодіуретиками. За показаннями призначають анальгетики, снодійні та седативні препарати. Після гострого періоду проводиться відновлювальне лікування, що включає ноотропні препарати, стимулятори мозкової діяльності та ін. Лікування менінгококцемії проводиться за загальними правилами лікування невідкладних станів, що включає боротьбу з ІТШ, ДВЗ-синдромом, ННГМ, гіпоксією.
Профілактика
Загальні заходи
Основними профілактичними заходами є раннє виявлення і ізоляція хворих, санація виявлених менінгококоносіїв ампіциліном або доксицикліном, пропаганда правил особистої гігієни, санітарно-просвітня робота. У період сезонного підйому захворюваності доцільно обмеження культурних і спортивних заходів.


Специфічна профілактика
Нині її проводять полісахаридними вакцинами, що є двовалентними (серогрупи А і С), тривалентними (серогрупи А, С і W) або чотиривалентними (групи А, С, Y і W135). Створити полісахаридну вакцину проти серогрупи В на даний момент не є можливим через високу антигенну мімікрію в тканинах людини, тому натепер є окремі мембрано-білкові вакцини проти збудників цієї серогрупи. Тому такі вакцини проти менінгококів групи В, що використані, зокрема, на Кубі, у Новій Зеландії й Норвегії, призначені для боротьби з епідеміями, зумовленими конкретними штамами. Інші універсальні протеїнові вакцини групи В знаходяться на завершальних стадіях розробки.
З 2010 р. у країнах Африканського «менінгітного поясу» використовується кон'югована вакцина проти серогрупи А, що спричиняє там найбільшу кількість випадків захворювання. Ця вакцина має певні переваги перед поліцукридною. Вакцини зумовлюють наростання антитіл і захист від хвороби з 5-го дня після одноразового введення, а через 2 тижні імунітет досягає максимального рівня і зберігається протягом 2 років. У грудні 2010 р. ця вакцина проти менінгокока групи А була введена на усій території Буркіна-Фасо і в окремих районах Малі і Нігера, де, в цілому, було вакциновано 20 млн людей у віці 1-29 років. Згодом, у 2011 р., в цих країнах було зареєстровано найнижче за усю історію число підтверджених випадків генералізованої менінгококової інфекції, спричиненго менігококом серогрупи А, під час епідемічного сезону.
Для екстреної профілактики менінгококової інфекції призначають також пролонгований пеніцилін — біцилін-5 в/м по 1,5 млн ОД. одноразово, що створює захист протягом місяця.
Примітки
- Международные медико-санитарные правила 2005 года. 2-е издание.
- Менингококковый менингит. Информационный бюллетень N°141 (рос.)
- Emergencies preparedness, response Meningococcal disease — Niger (update). Disease outbreak news. 23 July 2015
- У світі щороку реєструють 500 тисяч випадків менінгококової інфекції. РБК-Украина (рос.). Процитовано 2 березня 2020.
- Femke van Kessel, Caroline van den Ende, Anouk M Oordt-Speets, and Moe H Kyaw. Outbreaks of meningococcal meningitis in non-African countries over the last 50 years: a systematic review. J Glob Health. 2019 Jun; 9(1): 010411. doi: 10.7189/jogh.09.010411
- Meningococcemia (англ.)
Джерела
- Інфекційні хвороби (підручник) (за ред. О. А. Голубовської). — Київ: ВСВ «Медицина» (2 видання, доповнене і перероблене). — 2018. — 688 С. + 12 с. кольор. вкл. (О. А. Голубовська, М. А. Андрейчин, А. В. Шкурба та ін.) ISBN 978-617-505-675-2 С. 328—338
- Возіанова Ж. І. Інфекційні і паразитарні хвороби: В 3 т. — К.:"Здоров'я",2008. — Т.1.; 2-е вид., перероб. і доп. — 884 с. ISBN 978-966-463-012-9
- Невідкладна медична допомога: Навч. посібник / К. М. Амосова, Б. Г. Безродний, О. А. Бур'янов, Б. М. Венцківський та ін.; За ред. Ф. С. Глумчера, В. Ф. Москаленка. / Розділ XIX. Невідкладні стани в клініці інфекційних хвороб (Возіанова Ж. І., Печінка А. М., Шкурба А. В.) — К.: Медицина, 2006. — 632 С. ISBN 966-8144-12-0
- Prevention and Control of Meningococcal Disease. Recommendations of the Advisory Committee on Immunization Practices (ACIP). (англ.)
